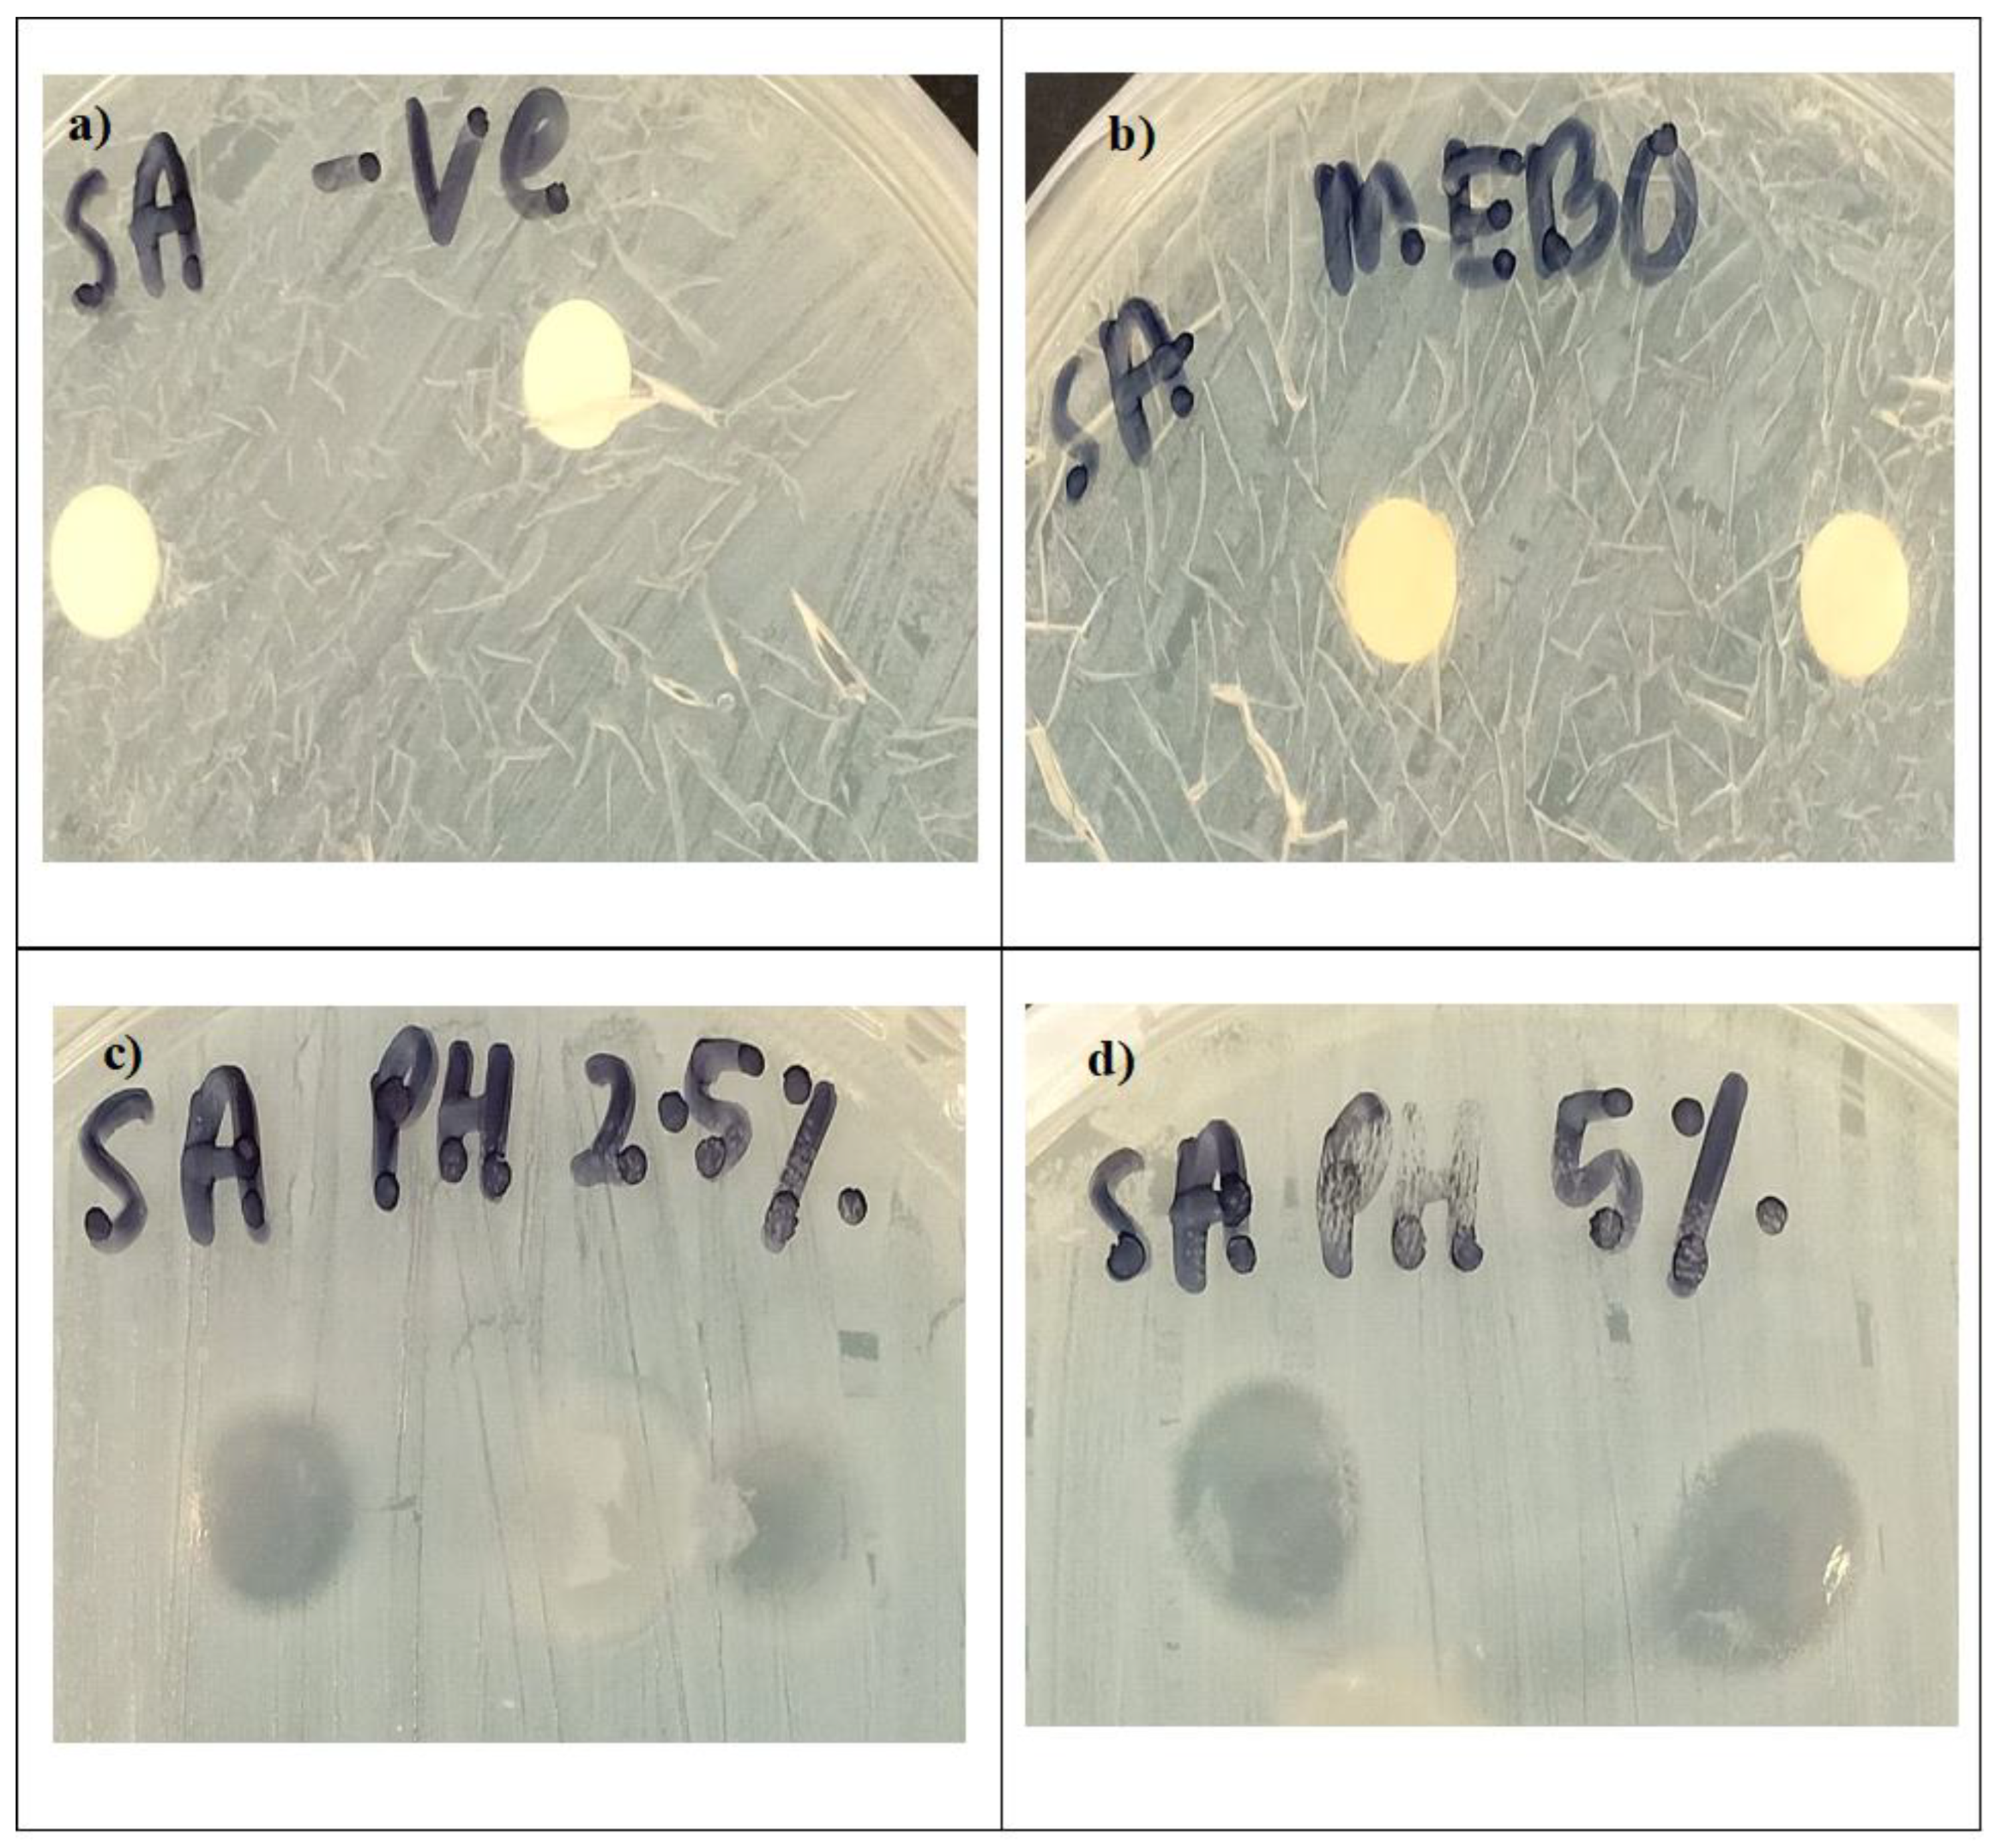

Effects of Drug-Free Pectin Hydrogel Films on Thermal Burn Wounds in Streptozotocin-Induced Diabetic Rats
Abstract
:1. Introduction
2. Materials and Methods
2.1. Materials
2.2. Preparation of Pectin Hydrogel Films
2.3. Differential Scanning Calorimetry (DSC)
2.4. Fourier Transform Infrared Spectroscopy (FTIR)
2.5. Experimental Animals
- Group 1: untreated normal rats.
- Group 2: untreated diabetic rats (negative control).
- Group 3: diabetic rats treated with MEBO® (positive control).
- Group 4: diabetic rats treated with 2.5% (w/w) pectin hydrogel (PH 2.5%).
- Group 5: diabetic rats treated with 5% (w/w) pectin hydrogel (PH 5%).
2.6. Induction of Diabetes Mellitus
2.7. In Vivo Wound Healing Study
2.8. Histological Study
2.9. Antimicrobial Activity
2.10. Statistical Analysis
3. Results and Discussion
Author Contributions
Funding
Institutional Review Board Statement
Informed Consent Statement
Data Availability Statement
Conflicts of Interest
References
- IDF Diabetes Atlas 2021, 10th ed.; International Diabetes Federation: Brussels, Belgium, 2022; Available online: https://www.diabetesatlas.org (accessed on 28 April 2022).
- Cheng, K.Y.; Lin, Z.H.; Cheng, Y.P.; Chiu, H.Y.; Yeh, N.L.; Wu, T.K.; Wu, J.S. Wound Healing in Streptozotocin-Induced Diabetic Rats Using Atmospheric-Pressure Argon Plasma Jet. Sci. Rep. 2018, 8, 12214. [Google Scholar] [CrossRef] [PubMed]
- Amin, M.A.; Abdel-Raheem, I.T. Accelerated wound healing and anti-inflammatory effects of physically cross linked polyvinyl alcohol-chitosan hydrogel containing honey bee venom in diabetic rats. Arch. Pharm. Res. 2014, 37, 1016–1031. [Google Scholar] [CrossRef] [PubMed]
- Ahmed, E.T.; Abo-Salem, O.M.; Osman, A. The Influence of Egyptian Propolis on Induced Burn Wound Healing in Diabetic Rats Antibacterial Mechanism. EWMA J. 2011, 11, 21–25. [Google Scholar]
- Hosseini Mansoub, N.; Gürdal, M.; Karadadaş, E.; Kabadayi, H.; Vatansever, S.; Ercan, G. The role of PRP and adipose tissue-derived keratinocytes on burn wound healing in diabetic rats. Bioimpacts 2018, 8, 5–12. [Google Scholar] [CrossRef] [Green Version]
- Brem, H.; Tomic-Canic, M. Cellular and molecular basis of wound healing in diabetes. J. Clin. Investig. 2007, 117, 1219–1222. [Google Scholar] [CrossRef] [Green Version]
- Shanbhag, T.; Amuthan, A.; Shenoy, S.; Sudhakar. Effect of Phyllanthus niruri. Linn on burn wound in rats. Asian Pac. J. Trop. Med. 2010, 3, 105–108. [Google Scholar] [CrossRef] [Green Version]
- Low, Z.K.; Ng, W.Y.; Fook-Chong, S.; Tan, B.K.; Chong, S.J.; Hwee, J.; Tay, S.K. Comparison of clinical outcomes in diabetic and non-diabetic burns patients in a national burns referral centre in southeast Asia: A 3-year retrospective review. Burns 2010, 43, 436–444. [Google Scholar] [CrossRef]
- Kamoun, E.A.; Kenawy, E.R.S.; Chen, X. A review on polymeric hydrogel membranes for wound dressing applications: PVA-based hydrogel dressings. J. Adv. Res. 2017, 8, 217–233. [Google Scholar] [CrossRef]
- Mishra, R.K.; Majeed, A.B.A.; Banthia, A.K. Development and characterisation of pectin/gelatin hydrogel membranes for wound dressing. Int. J. Plast. Technol. 2011, 15, 82–95. [Google Scholar] [CrossRef]
- Kim, J.; Lee, C.M. Wound healing potential of a polyvinyl alcohol-blended pectin hydrogel containing Hippophae rahmnoides L. extract in a rat model. Int. J. Biol. Macromol. 2017, 99, 586–593. [Google Scholar] [CrossRef]
- Selvan, N.K.; Shanmugarajan, T.S.; Uppuluri, V.N.V.A. Hydrogel based scaffolding polymeric biomaterials: Approaches towards skin tissue regeneration. J. Drug Deliv. Sci. Technol. 2020, 55, 101456. [Google Scholar] [CrossRef]
- Wojtasik, W.; Czemplik, M.; Preisner, M.; Dymińska, L.; Yuan, G.; Szopa, J.; Kulma, A. Pectin from transgenic flax shives regulates extracellular matrix remodelling in human skin fibroblasts. Process. Biochem. 2017, 55, 187–198. [Google Scholar] [CrossRef]
- Birch, N.P.; Barney, L.E.; Pandres, E.; Peyton, S.R.; Schiffman, J.D. Thermal-responsive behavior of a cell compatible chitosan/pectin hydrogel. Biomacromolecules 2015, 16, 1837–1843. [Google Scholar] [CrossRef] [PubMed] [Green Version]
- Li, Z.; Zhou, F.; Li, Z.; Lin, S.; Chen, L.; Liu, L.; Chen, Y. Hydrogel Cross-Linked with Dynamic Covalent Bonding and Micellization for Promoting Burn Wound Healing. ACS Appl. Mater. Interfaces 2018, 10, 25194–25202. [Google Scholar] [CrossRef]
- Op ‘t Veld, R.C.; van den Boomen, O.I.; Lundvig, D.M.S.; Bronkhorst, E.M.; Kouwer, P.H.J.; Jansen, J.A.; Middelkoop, E.; Von den Hoff, J.W.; Rowan, A.E.; Wagener, F.A. Thermosensitive biomimetic polyisocyanopeptide hydrogels may facilitate wound repair. Biomaterials 2018, 181, 392–401. [Google Scholar] [CrossRef] [PubMed]
- Furman, B.L. Streptozotocin-Induced Diabetic Models in Mice and Rats. Curr. Protoc. Pharmacol. 2015, 70, 5.47.1–5.47.20. [Google Scholar] [CrossRef]
- Patterson, E.; Marques, T.M.; O’Sullivan, O.; Fitzgerald, P.; Fitzgerald, G.F.; Cotter, P.D.; Dinan, T.G.; Cryan, J.F.; Stanton, C.; Ross, R.P. Streptozotocin-induced type-1-diabetes disease onset in Sprague–Dawley rats is associated with an altered intestinal microbiota composition and decreased diversity. Microbiology 2015, 161 Pt 1, 182–193. [Google Scholar] [CrossRef]
- Ramli, N.A.; Wong, T.W. Sodium carboxymethylcellulose scaffolds and their physicochemical effects on partial thickness wound healing. Int. J. Pharm. 2011, 403, 73–82. [Google Scholar] [CrossRef]
- Shao, Y.; Shao, H.; Hua, X.; Kohlus, R. Kinetics study of acid hydrolysis of citrus pectin in hydrothermal process. Food Hydrocoll. 2022, 124 Pt B, 107300. [Google Scholar] [CrossRef]
- Yapo, B.M. Pectic substances: From simple pectic polysaccharides to complex pectins—A new hypothetical model. Carbohydr. Polym. 2011, 86, 373–385. [Google Scholar] [CrossRef]
- Pal, K.; Paulson, A.T.; Rousseau, D. Chapter 16—Biopolymers in controlled-release delivery systems. In Handbook of Biopolymers and Biodegradable Plastics; Plastics Design Library; Elsevier: Amsterdam, The Netherlands, 2013; pp. 329–363. [Google Scholar]
- Fonder, M.A.; Lazarus, G.S.; Cowan, D.A.; Aronson-Cook, B.; Kohli, A.R.; Mamelak, A.J. Treating the chronic wound: A practical approach to the care of nonhealing wounds and wound care dressings. J. Am. Acad. Dermatol. 2008, 58, 185–206. [Google Scholar] [CrossRef] [PubMed]
- Thomas, D.C.; Tsu, C.L.; Nain, R.A.; Arsat, N.; Fun, S.S.; Nik Lah, N.A.S. The role of debridement in wound bed preparation in chronic wound: A narrative review. Ann. Med. Surg. 2021, 71, 102876. [Google Scholar] [CrossRef] [PubMed]
- Mancini, S.; Cuomo, R.; Poggialini, M.; D’Aniello, C.; Botta, G. Autolytic debridement and management of bacterial load with an occlusive hydroactive dressing impregnated with polyhexamethylene biguanide. Acta Biomed. 2018, 88, 409–413. [Google Scholar]
- Valle, K.Z.M.; Acuña, R.A.S.; Arana, J.V.R.; Lobo, N.; Rodriguez, C.; Cuevas-Gonzalez, J.C.; Tovar-Carrillo, K.L. Natural film based on pectin and allantoin for wound healing: Obtaining, characterisation, and rat model. BioMed Res. Int. 2020, 2020, 6897497. [Google Scholar] [CrossRef]
- Rezvanian, M.; Ng, S.-F.; Alavi, T.; Ahmad, W. In-vivo evaluation of alginate-pectin hydrogel film loaded with simvastatin for diabetic wound healing in streptozotocin-induced diabetic rats. Int. J. Biol. Macromol. 2021, 171, 308–319. [Google Scholar] [CrossRef]
- Kocaaga, B.; Kurkcuoglu, O.; Tatlier, M.; Dinler-Doganay, G.; Batirel, S.; Güner, F.S. Pectin–zeolite-based wound dressings with controlled albumin release. Polymers 2022, 14, 460. [Google Scholar] [CrossRef] [PubMed]
- Giusto, G.; Vercelli, C.; Comino, F.; Caramello, V.; Tursi, M.; Gandini, M. A new, easy-to-make pectin-honey hydrogel enhances wound healing in rats. BMC Complement. Altern. Med. 2017, 17, 266. [Google Scholar] [CrossRef] [Green Version]
- Pereira, R.F.; Barrias, C.C.; Bártolo, P.J.; Granja, P.L. Cell-instructive pectin hydrogels cross-linked via thiol-norbornene photo-click chemistry for skin tissue engineering. Acta Biomater. 2018, 66, 282–293. [Google Scholar] [CrossRef] [Green Version]
- Barret, J.P.; Podmelle, F.; Lipový, B.; Rennekampff, H.O.; Schumann, H.; Schwieger-Briel, A.; Zahn, T.R.; Metelmann, H.R. Accelerated re-epithelialisation of partial-thickness skin wounds by a topical betulin gel: Results of a randomised phase III clinical trials program. Burns 2017, 43, 1284–1294. [Google Scholar] [CrossRef]
- Ninan, N.; Muthiah, M.; Park, I.K.; Elain, A.; Wong, T.W.; Thomas, S.; Grohens, Y. Faujasites Incorporated Tissue Engineering Scaffolds for Wound Healing: In Vitro and In Vivo Analysis. ACS Appl. Mater. Interfaces 2013, 5, 11194–11206. [Google Scholar] [CrossRef]
- Banu, A.; Hassan, M.M.N.; Rajkumar, J.; Srinivasa, S. Spectrum of bacteria associated with diabetic foot ulcer and biofilm formation: A prospective study. Australas. Med. J. 2015, 8, 280–285. [Google Scholar] [CrossRef] [PubMed]
- Munarin, F.; Tanzi, M.C.; Petrini, P. Advances in biomedical applications of pectin gels. Int. J. Biol. Macromol. 2012, 51, 681–689. [Google Scholar] [CrossRef] [PubMed]
- Moslemi, M. Reviewing the recent advances in application of pectin for technical and health promotion purposes: From laboratory to market. Carbohydr. Polym. 2021, 254, 117324. [Google Scholar] [CrossRef] [PubMed]

Publisher’s Note: MDPI stays neutral with regard to jurisdictional claims in published maps and institutional affiliations. |
© 2022 by the authors. Licensee MDPI, Basel, Switzerland. This article is an open access article distributed under the terms and conditions of the Creative Commons Attribution (CC BY) license (https://creativecommons.org/licenses/by/4.0/).
Share and Cite
Nordin, N.N.; Aziz, N.K.; Naharudin, I.; Anuar, N.K. Effects of Drug-Free Pectin Hydrogel Films on Thermal Burn Wounds in Streptozotocin-Induced Diabetic Rats. Polymers 2022, 14, 2873. https://doi.org/10.3390/polym14142873
Nordin NN, Aziz NK, Naharudin I, Anuar NK. Effects of Drug-Free Pectin Hydrogel Films on Thermal Burn Wounds in Streptozotocin-Induced Diabetic Rats. Polymers. 2022; 14(14):2873. https://doi.org/10.3390/polym14142873
Chicago/Turabian StyleNordin, Nur Nadhirah, Nur Karimah Aziz, Idanawati Naharudin, and Nor Khaizan Anuar. 2022. "Effects of Drug-Free Pectin Hydrogel Films on Thermal Burn Wounds in Streptozotocin-Induced Diabetic Rats" Polymers 14, no. 14: 2873. https://doi.org/10.3390/polym14142873
APA StyleNordin, N. N., Aziz, N. K., Naharudin, I., & Anuar, N. K. (2022). Effects of Drug-Free Pectin Hydrogel Films on Thermal Burn Wounds in Streptozotocin-Induced Diabetic Rats. Polymers, 14(14), 2873. https://doi.org/10.3390/polym14142873

